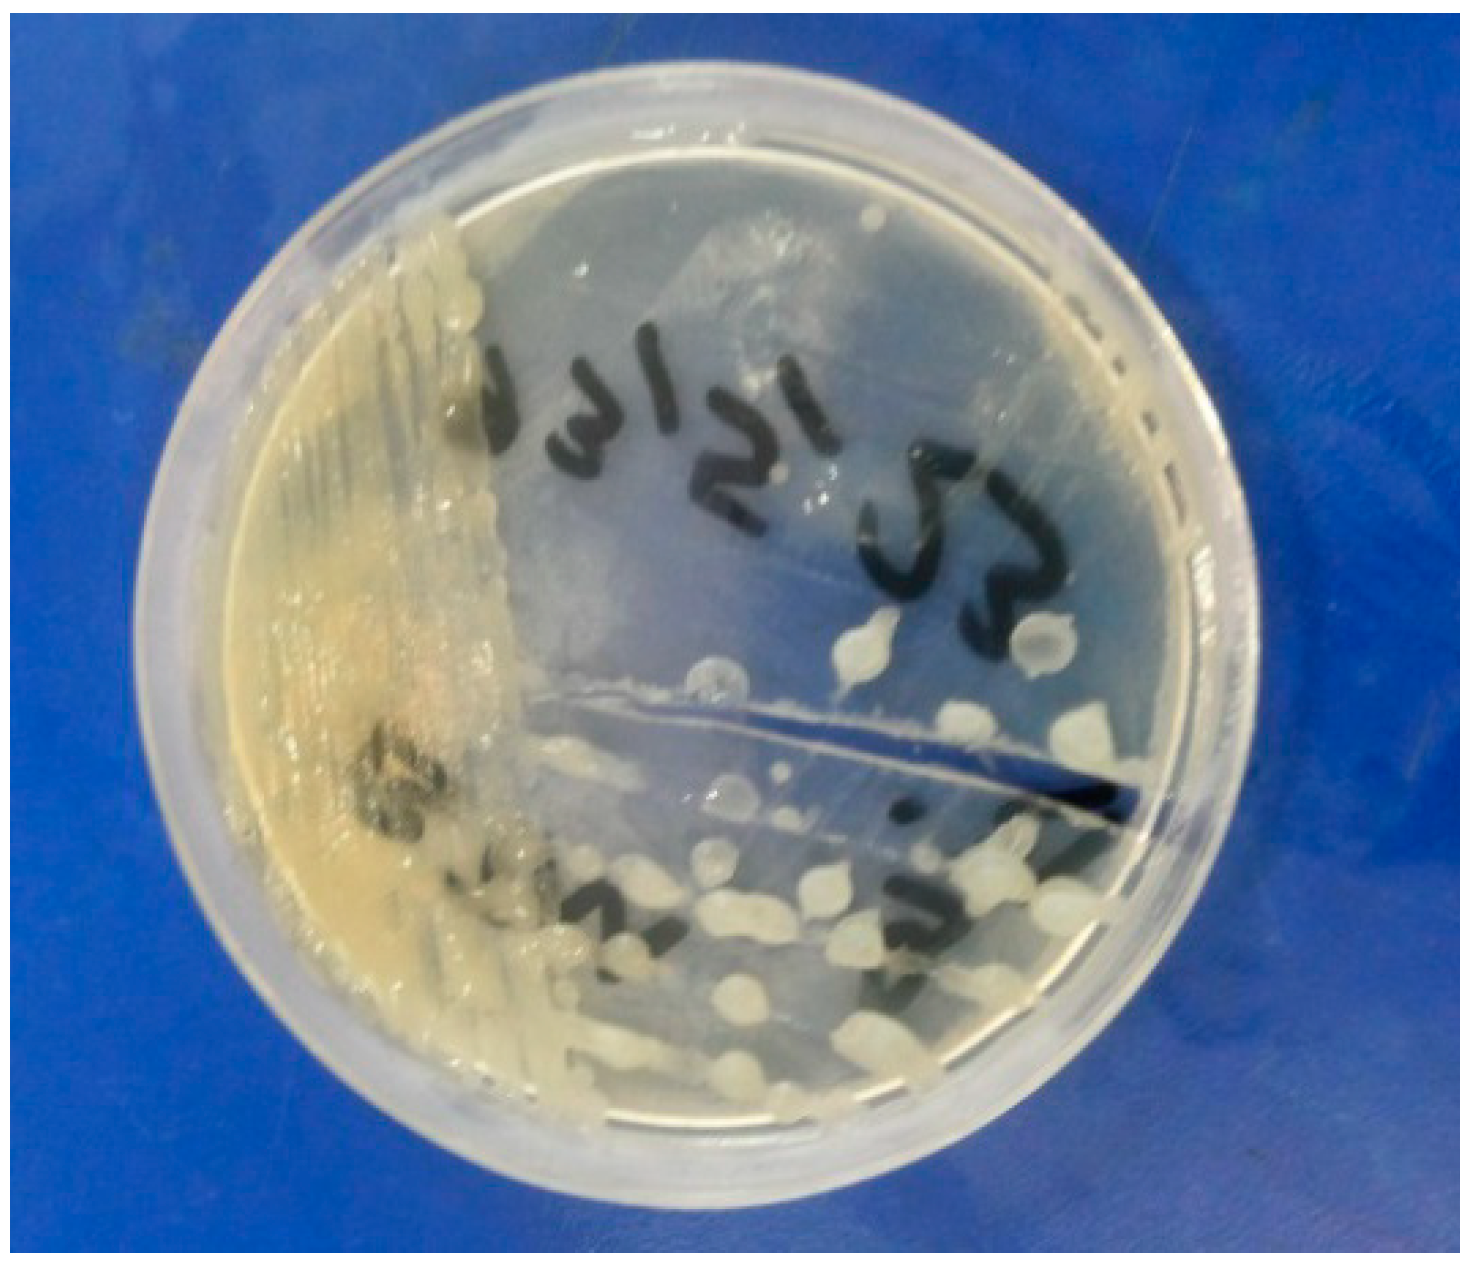
Molecules 19 13093 g002
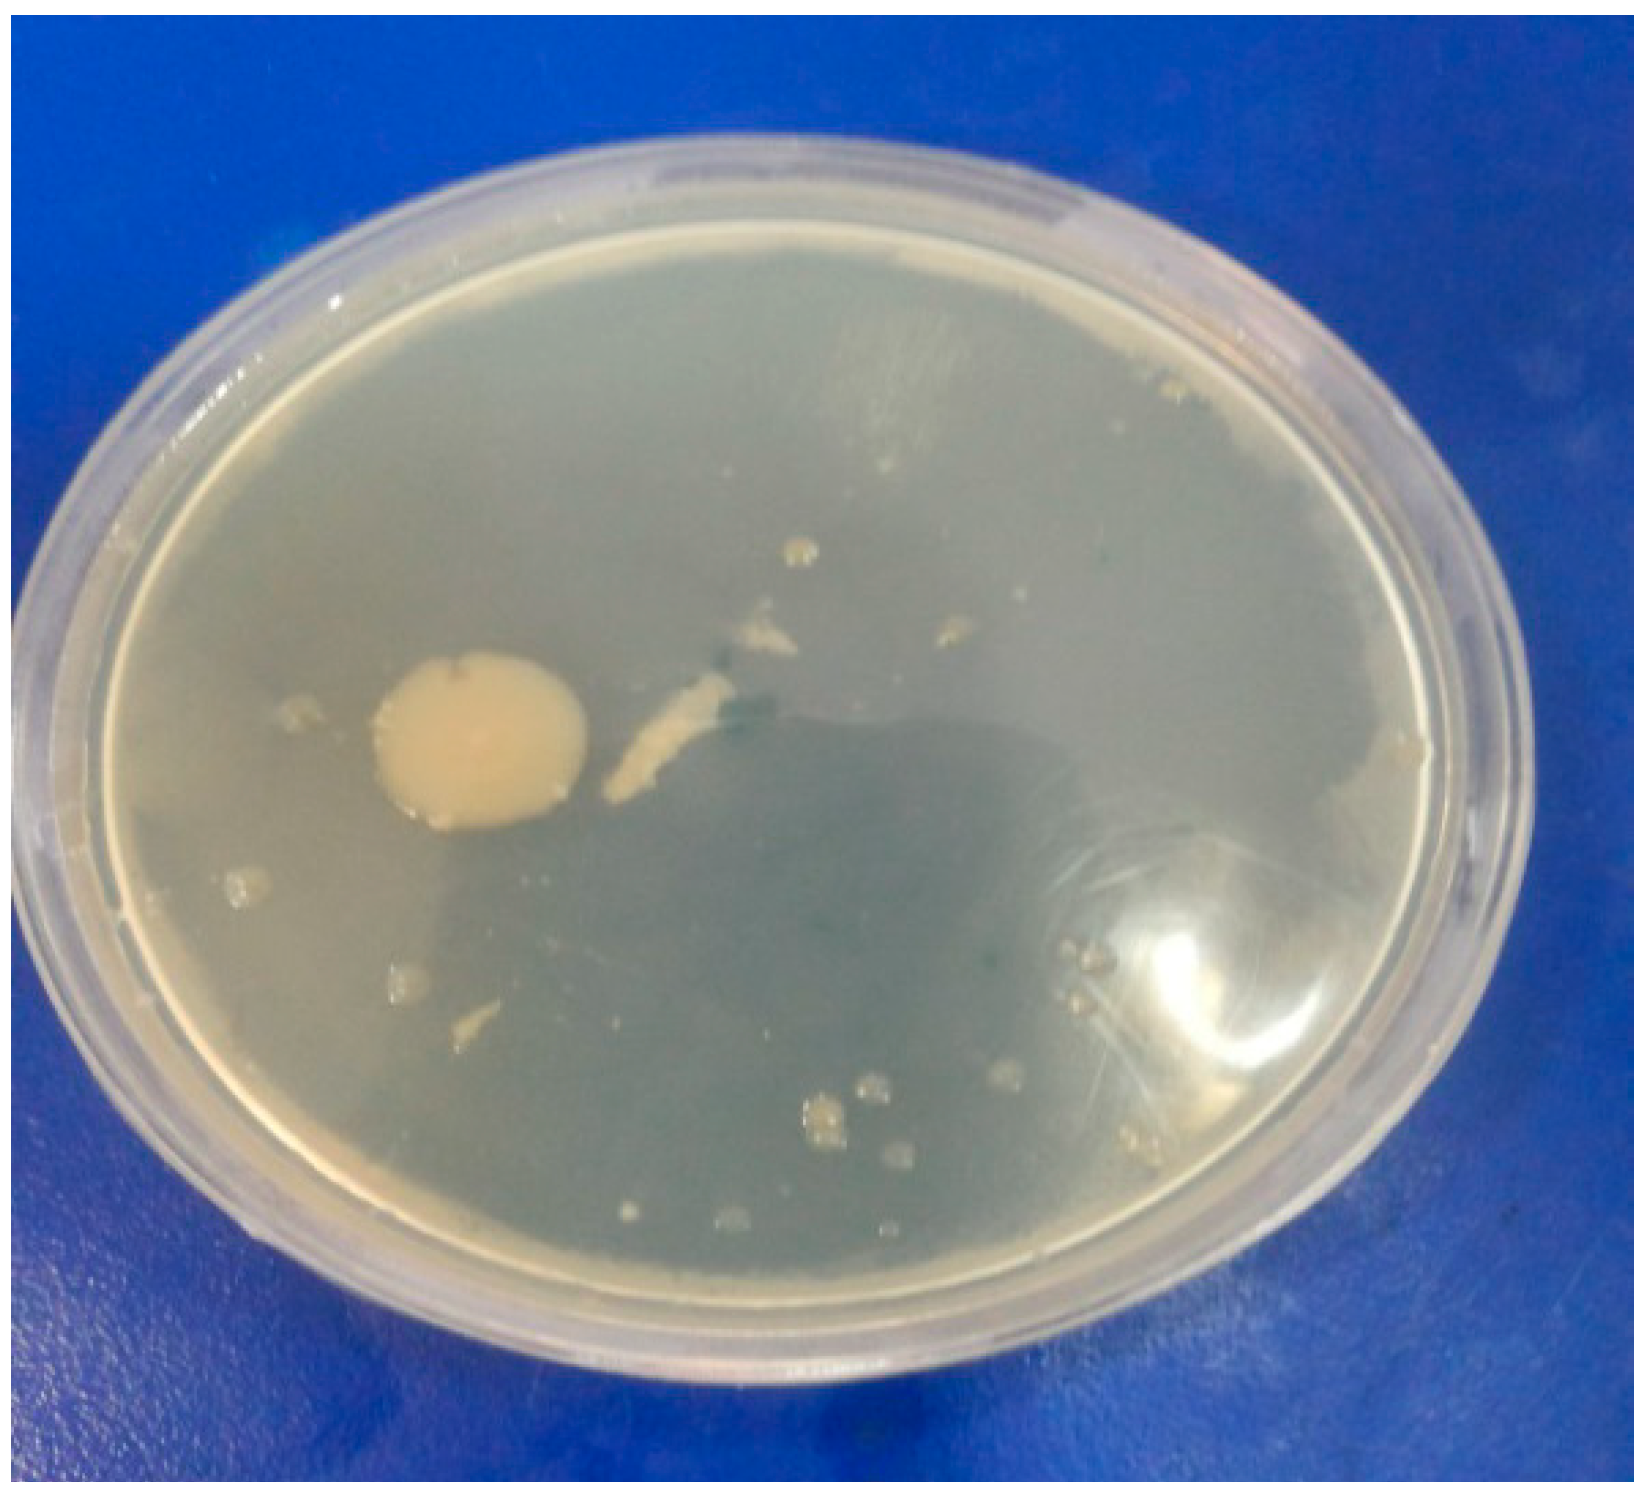
Molecules 19 13093 g004

Microwave Assisted Convenient One-Pot Synthesis of Coumarin Derivatives via Pechmann Condensation Catalyzed by FeF3 under Solvent-Free Conditions and Antimicrobial Activities of the Products
Abstract
:1. Introduction

2. Results and Discussion
| Entry | Phenol | Product | Time (min) | Yield (%) | MP °C, (Lit) [ref.] |
|---|---|---|---|---|---|
| 1 |  |  | 8 | 97 | 80–82, (81) [37] |
| 2 |  |  | 9 | 98 | 132–135, (131–133) [9] |
| 3 |  |  | 9 | 93 | 172–174, (171–172) [9] |
| 4 |  |  | 7 | 95 | 185–188, (184–185) [9] |
| 5 |  |  | 7 | 94 | 258–260, (257–260) [38] |
| 6 |  |  | 8 | 89 | 135–138, (137–138) [37] |
| 7 |  |  | 7 | 90 | 235–236, (234–237) [37] |
| 8 |  |  | 6 | 92 | 281–284, (280–281) [9] |
| 9 |  |  | 6 | 93 | 165–170, (169–170) [9] |
| 10 |  |  | 7 | 87 | 176–180, (180–182) [9] |
| 11 |  |  | 8 | 85 | 153–156, (154–155) [9] |
| 12 |  |  | 9 | 61 | 165–169 |
| 13 |  |  | 8 | 71 | 160–162 |
| 14 |  |  | 9 | 66 | 168–170 |
| NO. | Catalyst (g) | Yield (%) |
|---|---|---|
| 1 | - | 15 |
| 2 | 0.02 | 69 |
| 3 | 0.04 | 86 |
| 4 | 0.05 | 95 |
| 5 | 0.06 | 91 |
| 6 | 0.07 | 89 |
| 7 | 0.08 | 87 |
| 8 | 0.10 | 85 |
| NO. | Solvent | Yield (%) |
|---|---|---|
| 1 | solvent-free | 95 |
| 2 | DMF | 57 |
| 3 | acetonitrile | 63 |
| 4 | dichloromethane | 49 |
| 5 | water | 64 |
| 6 | ethanol | 81 |
| 7 | methanol | 80 |
| 8 | dioxane | 74 |
| Entry | Catalyst/mol% | Conditions | Reaction Time (min) | Yield (%) | Reference |
|---|---|---|---|---|---|
| 1 | Ce(OTf)4/1 | H2O/Room Temperature | 15 | 92 | [39] |
| 2 | PFPAT/10 | Toluene/110 °C | 180 | 90 | [39] |
| 3 | MFRH/0.05 g | Solvent free/80 °C | 50 | 65 | [39] |
| 4 | Oxalic acid/10 | Solvent free/80 °C | 30 | 95 | [39] |
| Nanoreactors/7 | Solvent free/130 °C | 60 | 30 | [39] | |
| 5 | FeF3/0.05 g | Heating/Ethanol, reflux | 120 | 67 | This Research |
| 5 | FeF3/0.05 g | Microwaves | 7 | 95 | This Research |
| Compound | Zone of Inhibition (%) | |||||||||||
|---|---|---|---|---|---|---|---|---|---|---|---|---|
| Antibacterial Activity | Antifungal Activity | |||||||||||
| Escherichia coli | Staphylococcus aureus | Aspergillus niger | Helminthosporium oryzae | |||||||||
| 100 | 50 | 25 | 100 | 50 | 25 | 100 | 50 | 25 | 100 | 50 | 25 | |
| 1 | 21 | 10 | 5 | 22 | 10 | 6 | 20 | 10 | 7 | 13 | 8 | 5 |
| 2 | 22 | 11 | 6 | 21 | 10 | 5 | 18 | 12 | 6 | 19 | 12 | 7 |
| 3 | 23 | 12 | 7 | 23 | 12 | 6 | 19 | 13 | 8 | 13 | 7 | 4 |
| 4 | 20 | 12 | 7 | 21 | 10 | 5 | 21 | 11 | 7 | 19 | 10 | 7 |
| 5 | 22 | 11 | 6 | 21 | 12 | 6 | 18 | 11 | 6 | 13 | 7 | 4 |
| 6 | 22 | 10 | 6 | 22 | 12 | 7 | 19 | 9 | 4 | 18 | 10 | 5 |
| 7 | 24 | 14 | 8 | 23 | 12 | 7 | 21 | 14 | 8 | 20 | 15 | 8 |
| 8 | 21 | 10 | 5 | 22 | 11 | 5 | 20 | 12 | 4 | 14 | 9 | 5 |
| 9 | 21 | 11 | 7 | 21 | 12 | 5 | 20 | 12 | 6 | 19 | 10 | 7 |
| 10 | 23 | 12 | 8 | 23 | 10 | 6 | 21 | 13 | 6 | 20 | 11 | 6 |
| 11 | 21 | 10 | 5 | 20 | 10 | 6 | 20 | 10 | 5 | 19 | 11 | 6 |
| 12 | 23 | 13 | 7 | 23 | 12 | 8 | 20 | 12 | 7 | 20 | 10 | 5 |
| 13 | 22 | 10 | 5 | 21 | 10 | 6 | 19 | 11 | 5 | 16 | 8 | 6 |
| 14 | 22 | 11 | 5 | 22 | 10 | 5 | 20 | 11 | 4 | 15 | 9 | 5 |
| Penicillin Griseofulvin | 20 | 12 | 8 | 20 | 12 | 8 | 20 | 10 | 5 | 20 | 10 | 5 |
3. Experimental Section
3.1. General Information
3.2. Typical Procedure Adopted for the Synthesis of 7-Hydroxy-4-Methyl-Chromen-2-One (4)
3.3. Antimicrobial Activity

4. Conclusions
Acknowledgments
Author Contributions
Conflicts of Interest
References
- Kostova, I. Synthetic and natural coumarins as cytotoxic agents. Curr. Med. Chem. 2005, 5, 29–46. [Google Scholar]
- Al-Amiery, A.A.; Kadhum, A.; Mohamad, A. Antifungal activities of new coumarins. Molecules 2012, 17, 5713–5723. [Google Scholar] [CrossRef]
- Bahekar, S.S.; Shinde, D.B. Samarium(III) catalyzed one-pot construction of coumarins. Tetrahedron Lett. 2004, 45, 7999–8001. [Google Scholar] [CrossRef]
- Lake, B.G. Coumarin metabolism, toxicity and carcinogenicity: Relevance for human risk assessment. Food Chem. Toxicol. 1999, 37, 423–453. [Google Scholar] [CrossRef]
- Zahradnik, M. Production and Application of Fluorescent Brightening Agents; John Wiley & Sons: New York, NY, USA, 1992. [Google Scholar]
- Chen, J.; Liu, W.; Ma, J.; Xu, H.; Wu, J.; Tang, X.; Fan, Z.; Wang, P. Synthesis and properties of fluorescence dyes: Tetracyclic pyrazolo[3,4-b]pyridine-based coumarin chromophores with intramolecular charge transfer character. J. Org. Chem. 2012, 77, 3475–3482. [Google Scholar] [CrossRef]
- Hadacek, F.; Mueller, C.; Werner, A.; Greger, H.; Proksch, P. Analysis, isolation and insecticidal activity of linear furanocoumarins and other coumarin derivatives from Peucedanum (Apiaceae: Apioideae). J. Chem. Ecol. 1994, 20, 2035–2054. [Google Scholar] [CrossRef]
- Weigt, S.; Huebler, N.; Strecker, R.; Braunbeck, T.; Broschard, T.H. Developmental effects of coumarin and the anticoagulant coumarin derivative warfarin on zebrafish (Danio rerio) embryos. Reprod. Toxicol. 2012, 33, 133–141. [Google Scholar] [CrossRef]
- Amoozadeh, A.; Ahmadzadeh, M.; Kolvari, E. Easy access to coumarin derivatives using alumina sulfuric acid as an efficient and reusable catalyst under solvent-free conditions. J. Chem. 2013. [Google Scholar] [CrossRef]
- Sangshettia, J.N.; Nagnnath, D.; Kokarea, B.; Shinde, D.B. Water mediated efficient one-pot synthesis of bis-(4-hydroxycoumarin)methanes. Green Chem. Lett. Rev. 2009, 2, 233–235. [Google Scholar] [CrossRef]
- Narsaiah, A.V.; Nagaiah, K. An efficient Knoevenagel condensation catalyzed by LaCl3·7H2O in heterogeneous medium. Synth. Commun. 2003, 33, 3825–3832. [Google Scholar] [CrossRef]
- Lehnert, W. Verbesserte variante der knoevenagel-kondensation mit TiCl4/THF/pyridin(I). Alkylidenund arylidenmalonester bei 0–25 °C. Tetrahedron Lett. 1970, 11, 4723–4724. [Google Scholar] [CrossRef]
- Karimi-Jaberi, Z.; Nazarifar, M.R.; Pooladian, B. Tris(hydrogensulfato) boron as a solid heterogeneous catalyst for the rapid synthesis of α,α'-benzylidene bis (4-hydroxycoumarin) derivatives. Chin. Chem. Lett. 2012, 23, 781–784. [Google Scholar] [CrossRef]
- Mehrabi, H.; Abusaidi, H. Synthesis of biscoumarin and 3,4-dihydropyrano[c] chromene derivatives catalysed by sodium dodecyl sulfate (SDS) in neat water. J. Iran. Chem. Soc. 2010, 7, 890–894. [Google Scholar] [CrossRef]
- Ang, D.O. Hypophosphorous acid mediated dehalogenation in water. Tetrahedron Lett. 1996, 37, 5367–5368. [Google Scholar] [CrossRef]
- Yorimitsu, H.; Shinokubo, H.; Oshima, K. Radical cyclization reaction using a combination of phosphinic acid and a base in aqueous ethanol. Chem. Lett. 2000, 2, 104–105. [Google Scholar] [CrossRef]
- Kita, Y.; Nambu, H.; Ramesh, N.G.; Anilkumar, G.; Matsugi, M. A novel and efficient methodology for the C−C bond forming radical cyclization of hydrophobic substrates in water. Org. Lett. 2001, 3, 1157–1160. [Google Scholar] [CrossRef]
- Cravotto, G.; Nano, G.M.; Palmisano, G.; Tagliapietra, S. The reactivity of 4-hydroxycoumarin under heterogeneous high-intensity sonochemical conditions. Synthesis 2003, 8, 1286–1291. [Google Scholar]
- Bansal, K.M.; Mothsra, P.; Saxen, S.; Somvanshi, R.K.; Dey, S.; Singh, T.P. Molecular iodine: A versatile catalyst for the synthesis of bis(4-hydroxycoumarin) methanes in water. J. Mol. Catal. A: Chem. 2007, 268, 76–81. [Google Scholar] [CrossRef]
- Johnson, J.R. Other classical coumarins syntheses include the Perkin. In Organic Reactions; John Wiley & Sons: New York, NY, USA, 1942; Volume 1, pp. 210–285. [Google Scholar]
- Jones, G. The Knoevenagel Condensation Reaction in Organic Reactions; John Wiley: New York, NY, USA, 1967; Volume 15, pp. 204–599. [Google Scholar]
- Shriner, R.L. Reformatsky Reaction. In Organic Reactions; John Wiley & Sons: New York, NY, USA, 1942; Volume 1, pp. 1–37. [Google Scholar]
- Yavari, I.; Hekmat-Shoar, R.; Zonousi, A. Anewand efficient route to 4-carboxymethylcoumarins mediated by vinyltriphenylphosphonium salt. Tetrahedron Lett. 1998, 39, 2391–2392. [Google Scholar] [CrossRef]
- Pechmann, H.V.; Duisberg, C. Uber die verbindungen der phenole mit acetessigather. Ber. Dtsch. Chem. Ges. 1883, 16, 2119–2128. [Google Scholar] [CrossRef]
- Surasani, R.; Kalita, D.; Dhanunjaya Rao, A.V.; Yarbagi, K.; Chandrasekhar, K.B. FeF3 as a novel catalyst for the synthesis of polyhydroquinoline derivatives via unsymmetrical Hantzsch reaction. J. Fluorine Chem. 2012, 135, 91–96. [Google Scholar] [CrossRef]
- Atar, A.B.; Jeong, Y.S.; Jeong, Y.T. Iron fluoride: The most efficient catalyst for one-pot synthesis of 4H-pyrimido[2,1-b]benzothiazoles under solvent-free conditions. Tetrahedron 2014, 70, 5207–5213. [Google Scholar] [CrossRef]
- Sabetpoor, S.; Hatamjafari, F. Synthesis of coumarin derivatives using glutamic acid under solvent-free conditions. Orient. J. Chem. 2014, in press. [Google Scholar]
- Hatamjafari, F.; vahabi, V. A novel synthesis of biscoumarin derivatives catalyzed by ZnCl2 under solvent-free conditions. Orient. J. Chem. 2013, 29, 783–786. [Google Scholar] [CrossRef]
- Hatamjafari, F.; Montazeri, N. Three-component process for the synthesis of some pyrrole derivatives under microwave irradiation. Turk. J. Chem. 2009, 33, 797–802. [Google Scholar]
- Azizian, J.; Hatamjafari, F.; Karimi, A.R.; Shaabanzadeh, M. Multi-component reaction of amines, alkyl propiolates, and ninhydrin: An efficient protocol for the synthesis of tetrahydro-dihydroxy-oxoindeno[1,2-b]pyrrole derivatives. Synthesis 2006, 5, 765–767. [Google Scholar]
- Azizian, J.; Shaabanzadeh, M.; Hatamjafari, F.; Mohammadizadeh, M.R. One-pot rapid and efficient synthesis of new spiro derivatives of 11H-indeno[1,2-b]quinoxalin-11-one, 6H-indeno[1,2-b]pyrido[3,2-e]pyrazin-6-one and isatin-based 2-pyrazolines. ARKIVOC 2006, 2006, 47–58. [Google Scholar]
- Hatamjafari, F. New protocol to synthesize spiro-1,4-dihydropyridines by using a multicomponent reaction of cyclohexanone, ethyl cyanoacetate, isatin, and primary amines under microwave irradiation. Synth. Commun. 2006, 36, 3563–3570. [Google Scholar] [CrossRef]
- Azizian, J.; Hatamjafari, F.; Karimi, A.R. Four component and solvent-free synthesis of some new spiro-1,4-dihydropyridines on solid support montmorillonite K10. J. Heterocycl. Chem. 2006, 43, 1349–1352. [Google Scholar] [CrossRef]
- Hatamjafari, F. A green, reusable and highly efficient heterogeneous catalyst for the synthesis of arylpyrazoles using nano-Fe2O3. Orient. J. Chem. 2012, 28, 141–143. [Google Scholar] [CrossRef]
- Hatamjafari, F. Microwave assisted synthesis of arylpyrazoles using montmorillonite K-10. Asian J. Chem. 2012, 25, 2339–2340. [Google Scholar]
- Hatamjafari, F. Starch-sulfuric acid (SSA) as catalyst for a one-pot synthesis of 1,5-diaryl-1H-pyrazoles. Helv. Chim. Acta 2013, 96, 1560–1563. [Google Scholar] [CrossRef]
- Banothu, J.; Bavantula, R. (4-Sulfobutyl)tris(4-sulfophenyl)phosphonium hydrogen sulphate: An efficient, eco-friendly and recyclable catalyst for the synthesis of coumarin derivatives via Pechmann condensation under solvent-free condition. Adv. Appl. Sci. Res. 2013, 4, 74–78. [Google Scholar]
- Karami, B.; Kiani, M. A one-pot, three-component synthesis of new pyrano[2,3-h]coumarin derivatives. Catal. Commun. 2011, 14, 62–67. [Google Scholar] [CrossRef]
- Vahdat, S.M. An green and efficient one-pot synthesis of coumarin derivatives catalyzed by cerium(IV) triflate at room temperature. J. Appl. Chem. 2012, 7, 57–62. [Google Scholar]
- Devi, P.U.M.; Reddy, S.P.; Rani, N.R.U.; Reddy, K.J.; Reddy, M.N.; Reddanna, P. Lipoxygenase metabolites of α-linolenic acid in the development of resistance in pigeonpea, Cajanus cajan (L.) Millsp., seedlings against Fusarium udum infection. Eur. J. Plant Pathol. 2000, 106, 857–865. [Google Scholar] [CrossRef]
- Colle, J.G.; Duguid, J.P.; Firaser, A.G.; Mannion, B.P. Mackie & Mecartney Practical MedicinalMicrobiology,, 13th ed.; Churchill: Edinburgh/London, UK, 1989; pp. 553–558. [Google Scholar]
- Sample Availability: Samples of the compounds 1–5, 12 and 13 are available from the authors.
© 2014 by the authors. Licensee MDPI, Basel, Switzerland. This article is an open access article distributed under the terms and conditions of the Creative Commons Attribution license ( http://creativecommons.org/licenses/by/3.0/).
Share and Cite
Vahabi, V.; Hatamjafari, F. Microwave Assisted Convenient One-Pot Synthesis of Coumarin Derivatives via Pechmann Condensation Catalyzed by FeF3 under Solvent-Free Conditions and Antimicrobial Activities of the Products. Molecules 2014, 19, 13093-13103. https://doi.org/10.3390/molecules190913093
Vahabi V, Hatamjafari F. Microwave Assisted Convenient One-Pot Synthesis of Coumarin Derivatives via Pechmann Condensation Catalyzed by FeF3 under Solvent-Free Conditions and Antimicrobial Activities of the Products. Molecules. 2014; 19(9):13093-13103. https://doi.org/10.3390/molecules190913093
Chicago/Turabian StyleVahabi, Vahid, and Farhad Hatamjafari. 2014. "Microwave Assisted Convenient One-Pot Synthesis of Coumarin Derivatives via Pechmann Condensation Catalyzed by FeF3 under Solvent-Free Conditions and Antimicrobial Activities of the Products" Molecules 19, no. 9: 13093-13103. https://doi.org/10.3390/molecules190913093
APA StyleVahabi, V., & Hatamjafari, F. (2014). Microwave Assisted Convenient One-Pot Synthesis of Coumarin Derivatives via Pechmann Condensation Catalyzed by FeF3 under Solvent-Free Conditions and Antimicrobial Activities of the Products. Molecules, 19(9), 13093-13103. https://doi.org/10.3390/molecules190913093





